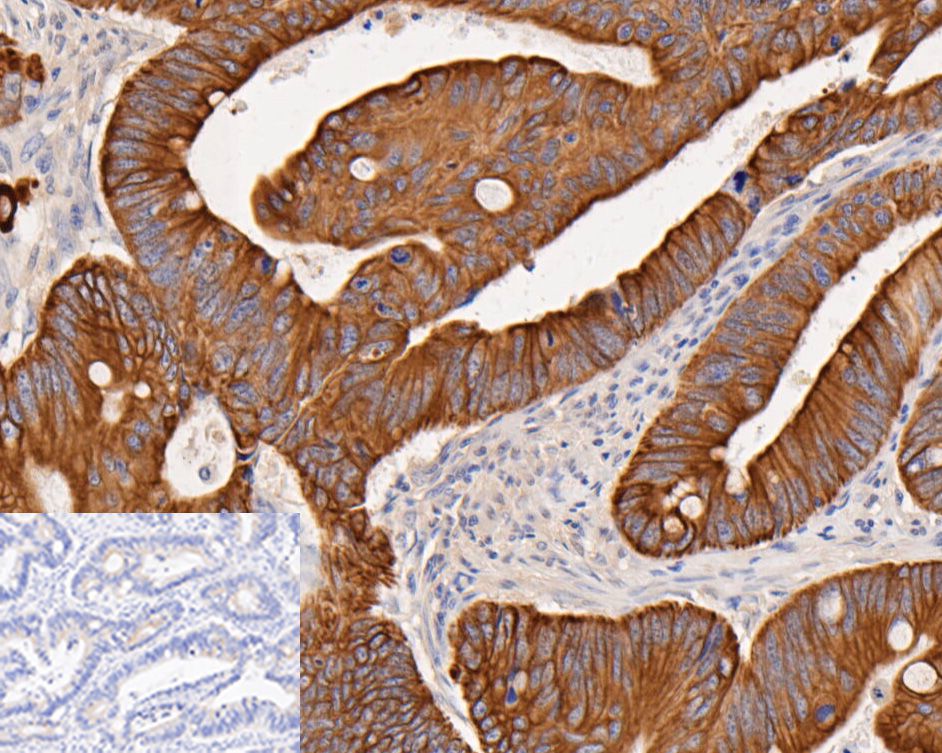
Immunohistochemical analysis of paraffin-embedded human Colorectal cancer tissue using rabbit anti-Cytokeratin 18 antibody.<br /><br />The section was pre-treated using heat mediated antigen retrieval with Tris-EDTA buffer (pH 8.0-8.4) for 20 minutes.The tissues were blocked in 5% BSA for 30 minutes at room temperature, washed with ddH<sub>2</sub>O and PBS, and then probed with the primary antibody (<a href=

HRP Conjugated Alpaca anti-Rabbit IgG Fc, Recombinant VHH monoclonal Antibody
Alpaca Monoclonal Antibody
Fc region of Rabbit IgG.
Rabbit
IP, ELISA, IHC-P, WB
HRP
Liquid
2ug/ul
Store at +4℃ after thawing. Aliquot store at -20℃. Avoid repeated freeze / thaw cycles.
1*PBS (pH7.4), 0.5%BSA, 50% Glycerol.
IgG
Immunogen affinity purified.
IP
Use at an assay dependent concentration.
ELISA
1:5,000-1:20,000
IHC-P
1:100-1:500
WB
1:50,000-1:100,000
| Mouse | 查看 6 篇文献如下 |
| Human | 查看 5 篇文献如下 |
| Soybean | 查看 1 篇文献如下 |
Higher resolution imaging due to the Alpaca anti-rabbit IgG Fc, recombinant VHHs’ 10 times smaller size than conventional secondary antibodies. The small size enables better tissue penetration, antigen access and decreases the distance between the epitope and label.
暂无

Western blot analysis of rabbit anti-GAPDH antibody (ET1601-4,1/2000) and rabbit anti-GST3 antibody (ER1802-63, 1/1000) with K562 Cell and A549 Cell lysates (All lanes proteins at 10 µg per lane). Proteins were transferred to a PVDF membrane and blocked with 5% BSA in PBS for 1 hour at room temperature. The primary antibody was used in 5% BSA at room temperature for 2 hours. Alpaca anti-rabbit IgG Fc, recombinant VHH (HRP) (HA1031) was used for 1 hour at room temperature at 1:40,000 (Lane A, E), 1:80,000 (Lane B, F), 1:160,000 (Lane C, G) and 1:320,000 (Lane D, H).
Exposure time: 30 seconds

The Cross-reactions of the secondary antibody (HA1031) with Rabbit IgG, Mouse IgG and Human IgG.
Proteins were transferred to a PVDF membrane and blocked with 5% NFDM/TBST for 1 hour at room temperature. Alpaca anti-Rabbit IgG FC, Recombinant VHH (HRP) (HA1031) was used for 1 hour at room temperature at 1/50,000.
Lane 1: Rabbit IgG (50 ng/Lane)
Lane 2: Mouse IgG (50 ng/Lane)
Lane 3: Human IgG (50 ng/Lane)
Exposure time: 10 seconds.
Immunohistochemical analysis of paraffin-embedded human Colorectal cancer tissue using rabbit anti-Cytokeratin 18 antibody.
The section was pre-treated using heat mediated antigen retrieval with Tris-EDTA buffer (pH 8.0-8.4) for 20 minutes.The tissues were blocked in 5% BSA for 30 minutes at room temperature, washed with ddH2O and PBS, and then probed with the primary antibody (ET1603-8, 1/200 dilution) for 30 minutes at room temperature. Alpaca anti-rabbit IgG Fc, recombinant VHH (HRP) (HA1031, 1/200 dilution) was used for 30 min at room temperature. Tissues were counterstained with hematoxylin and mounted with DPX.
The inset negative control image is secondary-only at 1/200 dilution.

Immunohistochemical analysis of paraffin-embedded human Kidney tissue using rabbit anti-CD13 antibody.
The section was pre-treated using heat mediated antigen retrieval with Tris-EDTA buffer (pH 8.0-8.4) for 20 minutes.The tissues were blocked in 5% BSA for 30 minutes at room temperature, washed with ddH2O and PBS, and then probed with the primary antibody (ER1803-45, 1/200) for 30 minutes at room temperature. Alpaca anti-rabbit IgG Fc, recombinant VHH (HRP) (HA1031, 1/200 dilution) was used for 30 min at room temperature. Tissues were counterstained with hematoxylin and mounted with DPX.
Transgenic soybean expressing Cry1Ab-Vip3A fusion protein confers broad-spectrum resistance to lepidopteran pest
Author: Pan Zhenzhi, Zhu Yanxiang, Lin Chaoyang, Tang Mengzhen, Shen Zhicheng, Zheng Ting
PMID: 40131492
期刊: Plant Cell Reports
应用: WB
反应种属: Soybean
发表时间: 2025 Mar
Copyright © 广州杰特伟生物科技有限公司 All Rights Reserved. 备案号:粤ICP备19077843号